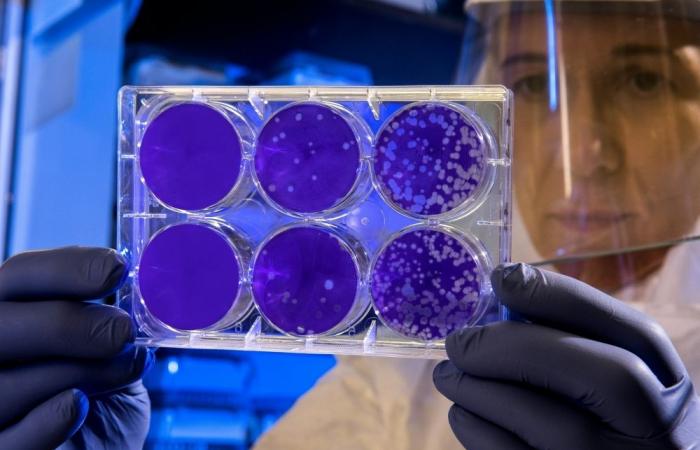
India confirms two Nipah cases in West Bengal, says outbreak contained with 196 contacts traced

Hello and welcome to the details of India confirms two Nipah cases in West Bengal, says outbreak contained with 196 contacts traced and now with the details
Nevin Al Sukari - Sana'a - Nipah, which spreads from animals to humans, has no vaccine and a fatality rate ranging from 40 to 75 per cent, according to the World Health Organization. — Unsplash pic
MUMBAI, INDIA, Jan 28 — Indian authorities said they had ensured “timely containment” of the deadly Nipah virus after two cases were confirmed in West Bengal state.
Nipah, which spreads from animals to humans, has no vaccine and a fatality rate ranging from 40 to 75 per cent, according to the World Health Organization.
“Enhanced surveillance, laboratory testing, and field investigations were undertaken… which ensured timely containment of the cases,” India’s health ministry said in a statement late yesterday.
It did not give further details on the two infected patients.
“The situation is under constant monitoring, and all necessary public health measures are in place,” it added, saying 196 contacts linked to the cases had been traced, and all were negative.
Nipah was first identified in 1998 after it spread among pig farmers in Malaysia.
In India, the first Nipah outbreak was reported in West Bengal in 2001.
In 2018, at least 17 people died from Nipah in Kerala, and in 2023, two people died from the virus, also in the southern state.
Symptoms include intense fever, vomiting and a respiratory infection, but severe cases can involve seizures and brain inflammation that results in a coma.
Fruit bats are the natural carriers of the virus and have been identified as the most likely cause of subsequent outbreaks. — AFP
These were the details of the news India confirms two Nipah cases in West Bengal, says outbreak contained with 196 contacts traced for this day. We hope that we have succeeded by giving you the full details and information. To follow all our news, you can subscribe to the alerts system or to one of our different systems to provide you with all that is new.
It is also worth noting that the original news has been published and is available at Malay Mail and the editorial team at AlKhaleej Today has confirmed it and it has been modified, and it may have been completely transferred or quoted from it and you can read and follow this news from its main source.